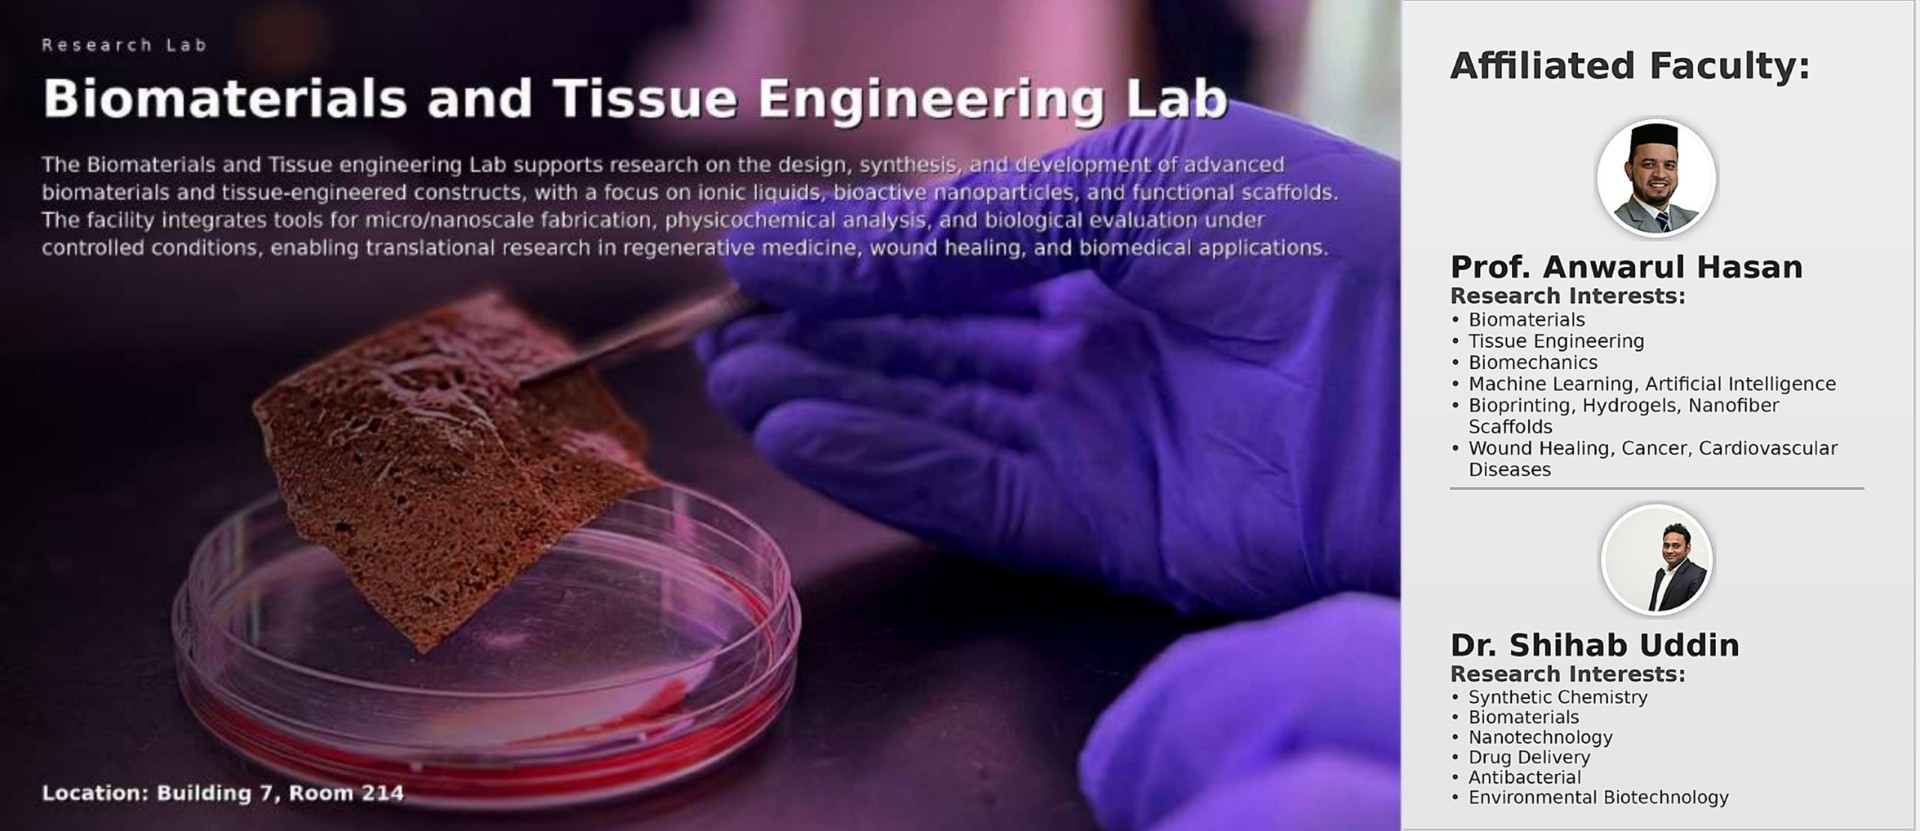
444f8fb6-d9c7-46d8-b038-7f0b5956e0f4

Lab Equipment

Nanoparticle Analyzer
The nanoPartica SZ-100V2 is a multi-parameter nanoparticle analyzer capable of measuring particle size, zeta potential, and molecular weight within a single compact system. Using dynamic and static light scattering techniques, it supports characterization of nanoparticles, polymers, and biomaterials across a wide concentration range.

Real-Time PCR System
The QuantStudio™ 5 Real-Time PCR System is a compact and reliable platform for quantitative PCR analysis with high sensitivity and dye versatility. It supports accurate nucleic acid quantification and gene analysis for applications in biomaterials research, molecular characterization, and biological sample evaluation.

Rotary Evaporator
The RV 10 digital V rotary evaporator is used for efficient solvent removal and concentration of biomaterial and polymer solutions under reduced pressure. It features a universal heating bath with fast heat-up times, vertical glassware, and a high-efficiency condenser to ensure reliable and reproducible evaporation processes.

Freeze Dryer
The Ilshin BioBase freeze dryer is used for lyophilization of biomaterials and nanomaterials, including polymeric and bio-based samples, by removing moisture under low temperature and vacuum conditions. This process preserves structural integrity, and bioactivity, supporting long-term storage and stability of samples.